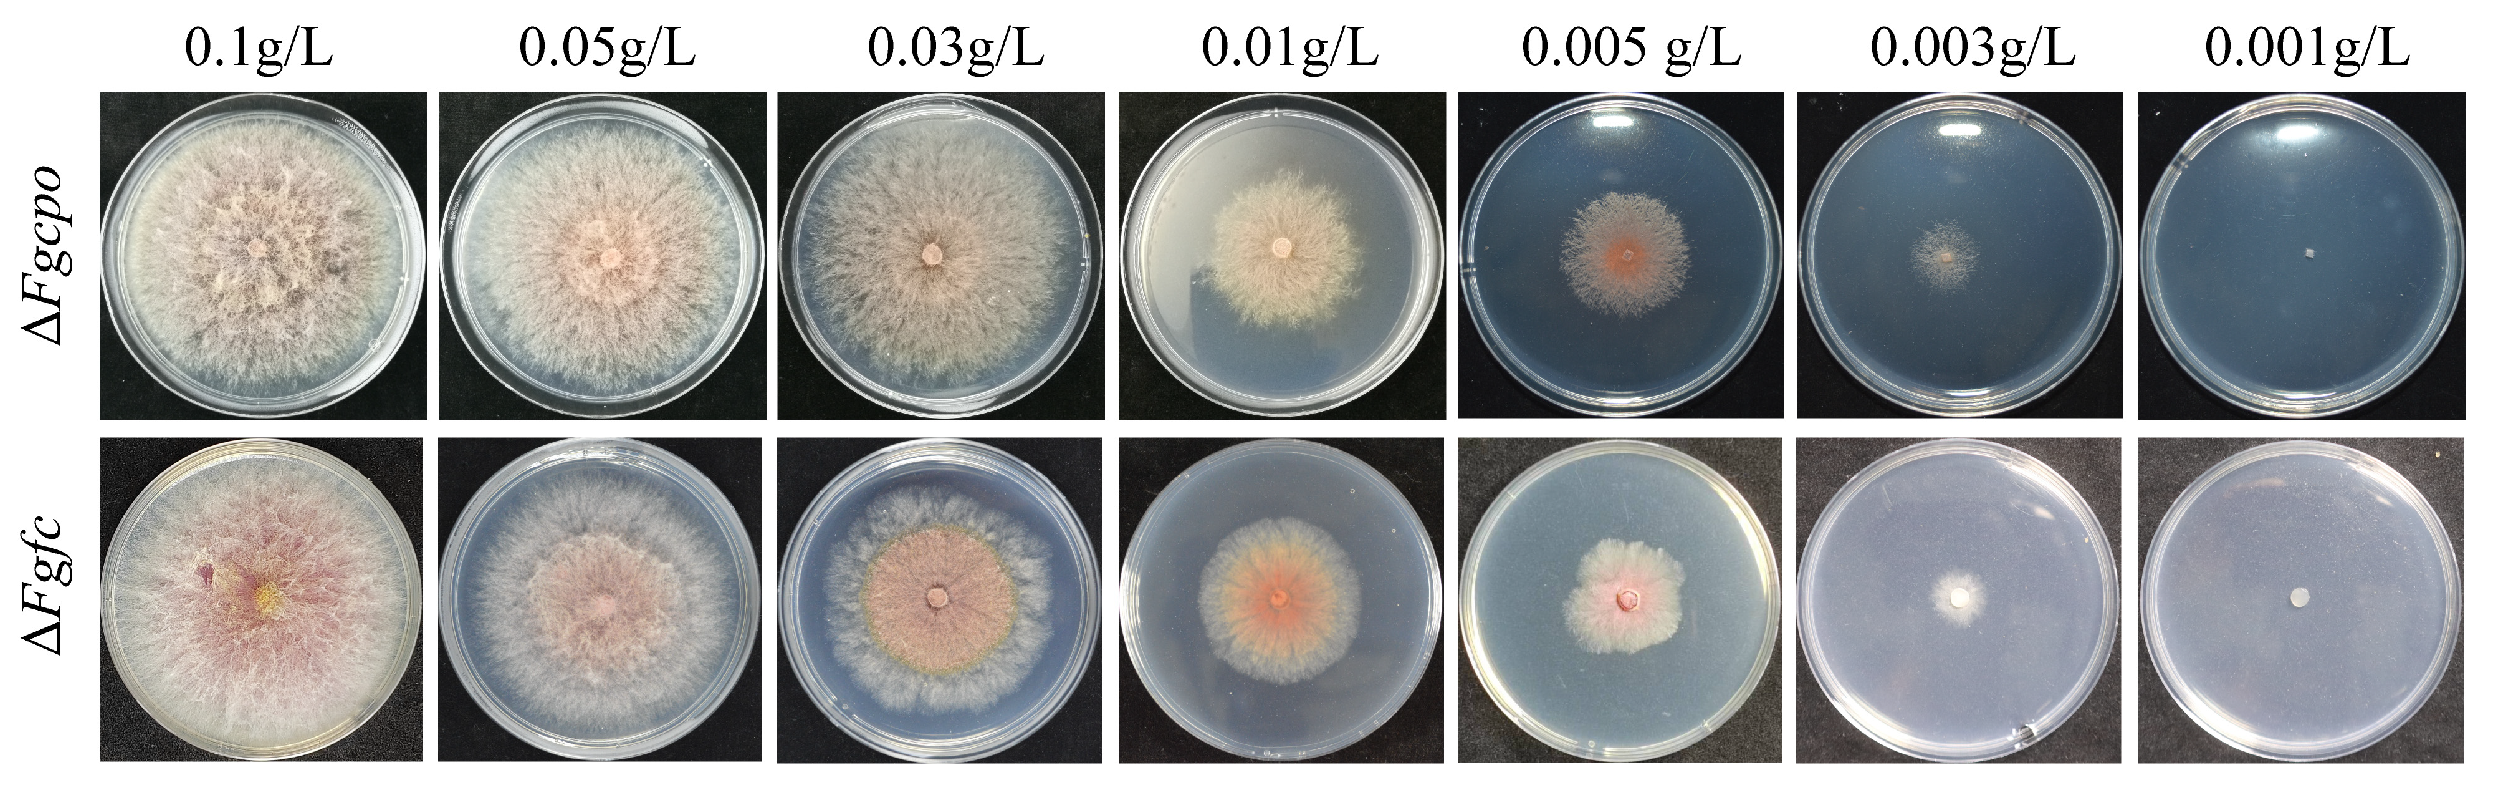
Ijms 25 05268 g002

Crucial Involvement of Heme Biosynthesis in Vegetative Growth, Development, Stress Response, and Fungicide Sensitivity of Fusarium graminearum
Abstract
:1. Introduction
2. Results
2.1. The Identification and Localization of FgCpo and FgFc
2.2. Heme Deficiency Is Fatal for F. graminearum
2.3. Heme Deficiency Impairs the Activity of FgCyp51
2.4. Heme Deficiency Impairs the Growth Rate, Asexual Reproduction, and Germination of Conidia
2.5. Heme Deficiency Damages the Full Virulence of F. graminearum
2.6. Heme Deficiency Affects Conidia Morphology
2.7. Heme Deficiency Impairs the Sensitivity to Stress Factors
2.8. Heme Deficiency Affects the Lipid Drop and Glycerol Accumulation
2.9. Heme Deficiency Affects Fatty Acid ꞵ-oxidation
2.10. Heme Negatively Regulates Autophagy
3. Discussion
4. Materials and Methods
4.1. Strain, Medium, Fungicide, and Plasmid
4.2. Vector Construction and Protoplast Transformation
4.3. Growth and Conidiation Determination
4.4. Determination of Sensitivity to Fungicides and Various Stress Factors
4.5. Lipid Droplet Staining and Glycerol Accumulation Detection
4.6. Determination of Fatty Acid Utilization
4.7. RNA Extraction
4.8. Quantitative Real-Time PCR Analysis
4.9. Autophagy Detection
4.10. Statistical Analysis
5. Conclusions
Supplementary Materials
Author Contributions
Funding
Institutional Review Board Statement
Informed Consent Statement
Data Availability Statement
Conflicts of Interest
References
- Goswami, R.S.; Kistler, H.C. Heading for disaster: Fusarium graminearum on cereal crops. Mol. Plant Pathol. 2004, 5, 515–525. [Google Scholar] [CrossRef] [PubMed]
- McMullen, M.; Jones, R.; Gallenberg, D. Scab of Wheat and Barley: A Re-emerging Disease of Devastating Impact. Plant Dis. 1997, 81, 1340–1348. [Google Scholar] [CrossRef] [PubMed]
- Pestka, J.J.; Smolinski, A.T. Deoxynivalenol: Toxicology and potential effects on humans. J. Toxicol. Environ. Health B Crit. Rev. 2005, 8, 39–69. [Google Scholar] [CrossRef] [PubMed]
- Dean, R.; Van Kan, J.A.L.; Pretorius, Z.A.; Hammond-Kosack, K.E.; Di Pietro, A.; Spanu, P.D.; Rudd, J.J.; Dickman, M.; Kahmann, R.; Ellis, J.; et al. The Top 10 fungal pathogens in molecular plant pathology. Mol. Plant Pathol. 2012, 13, 414–430. [Google Scholar] [CrossRef] [PubMed]
- Paul, P.A.; Lipps, P.E.; Hershman, D.E.; McMullen, M.P.; Draper, M.A.; Madden, L.V. Efficacy of triazole-based fungicides for Fusarium head blight and deoxynivalenol control in wheat: A multivariate meta-analysis. Phytopathology 2008, 98, 999–1011. [Google Scholar] [CrossRef] [PubMed]
- Spolti, P.; Del Ponte, E.M.; Dong, Y.; Cummings, J.A.; Bergstrom, G.C. Triazole sensitivity in a contemporary population of Fusarium graminearum from New York wheat and competitiveness of a tebuconazole-resistant isolate. Plant Dis. 2014, 98, 607–613. [Google Scholar] [CrossRef] [PubMed]
- Zhao, Y.X.; Chi, M.Y.; Sun, H.L.; Qian, H.W.; Yang, J.; Huang, J.G. The FgCYP51B Y123H Mutation Confers Reduced Sensitivity to Prochloraz and Is Important for Conidiation and Ascospore Development in Fusarium graminearum. Phytopathology 2021, 111, 1420–1427. [Google Scholar] [CrossRef] [PubMed]
- Daum, G.; Lees, N.D.; Bard, M.; Dickson, R. Biochemistry, cell biology and molecular biology of lipids of Saccharomyces cerevisiae. Yeast 1998, 14, 1471–1510. [Google Scholar] [CrossRef]
- Espenshade, P.J.; Hughes, A.L. Regulation of sterol synthesis in eukaryotes. Annu. Rev. Genet. 2007, 41, 401–427. [Google Scholar] [CrossRef]
- Wollam, J.; Antebi, A. Sterol Regulation of Metabolism, Homeostasis, and Development. Annu. Rev. Biochem. 2011, 80, 885–916. [Google Scholar] [CrossRef]
- Brown, M.S.; Goldstein, J.L. The SREBP pathway: Regulation of cholesterol metabolism by proteolysis of a membrane-bound transcription factor. Cell 1997, 89, 331–340. [Google Scholar] [CrossRef] [PubMed]
- Davies, B.S.J.; Wang, H.S.; Rine, J. Dual activators of the sterol biosynthetic pathway of: Similar activation/regulatory domains but different response mechanisms. Mol. Cell. Biol. 2005, 25, 7375–7385. [Google Scholar] [CrossRef] [PubMed]
- Espenshade, P.J. SREBPs: Sterol-regulated transcription factors. J. Cell Sci. 2006, 119, 973–976. [Google Scholar] [CrossRef] [PubMed]
- Maguire, S.L.; Wang, C.; Holland, L.M.; Brunel, F.; Neuvéglise, C.; Nicaud, J.M.; Zavrel, M.; White, T.C.; Wolfe, K.H.; Butler, G. Zinc Finger Transcription Factors Displaced SREBP Proteins as the Major Sterol Regulators during Saccharomycotina Evolution. PLoS. Genet. 2014, 10, e1004076. [Google Scholar] [CrossRef] [PubMed]
- Rawson, R.B. The SREBP pathway—Insights from Insigs and insects. Nat. Rev. Mol. Cell Bio. 2003, 4, 631–640. [Google Scholar] [CrossRef] [PubMed]
- Yang, H.; Tong, J.; Lee, C.W.; Ha, S.; Eom, S.H.; Im, Y.J. Structural mechanism of ergosterol regulation by fungal sterol transcription factor Upc2. Nat. Commun. 2015, 6, 6129. [Google Scholar] [CrossRef] [PubMed]
- Lee, S.J.; Sekimoto, T.; Yamashita, E.; Nagoshi, E.; Nakagawa, A.; Imamoto, N.; Yoshimura, M.; Sakai, H.; Chong, K.T.; Tsukihara, T.; et al. The structure of importin-beta bound to SREBP-2: Nuclear import of a transcription factor. Science 2003, 302, 1571–1575. [Google Scholar] [CrossRef] [PubMed]
- Liu, Z.; Jian, Y.; Chen, Y.; Kistler, H.C.; He, P.; Ma, Z.; Yin, Y. A phosphorylated transcription factor regulates sterol biosynthesis in Fusarium graminearum. Nat. Commun. 2019, 10, 1228. [Google Scholar] [CrossRef] [PubMed]
- Sagatova, A.A.; Keniya, M.V.; Tyndall, J.D.A.; Monk, B.C. Impact of Homologous Resistance Mutations from Pathogenic Yeast on Saccharomyces cerevisiae Lanosterol 14 alpha-Demethylase. Antimicrob. Agents Chemother. 2018, 62, 118881. [Google Scholar] [CrossRef]
- Sono, M.; Roach, M.P.; Coulter, E.D.; Dawson, J.H. Heme-Containing Oxygenases. Chem. Rev. 1996, 96, 2841–2888. [Google Scholar] [CrossRef]
- Wang, N.Y.; Zhao, X.; Lu, Y. Role of heme types in heme-copper oxidases: Effects of replacing a heme with a heme mimic in an engineered heme-copper center in myoglobin. J. Am. Chem. Soc. 2005, 127, 16541–16547. [Google Scholar] [CrossRef] [PubMed]
- Cerda, J.F.; Malloy, M.C.; Werkheiser, B.O.; Stockhausen, A.T.; Gallagher, M.F.; Lawler, A.C. Evaluation of heme peripheral group interactions in extremely low-dielectric constant media and their contributions to the heme reduction potential. Inorg. Chem. 2014, 53, 182–188. [Google Scholar] [CrossRef] [PubMed]
- Chen, M.; Wang, Z.H.; Shu, J.X.; Jiang, X.H.; Wang, W.; Shi, Z.H.; Lin, Y.W. Mimicking a Natural Enzyme System: Cytochrome Oxidase-Like Activity of Cu O Nanoparticles by Receiving Electrons from Cytochrome c. Inorg. Chem. 2017, 56, 9400–9403. [Google Scholar] [CrossRef] [PubMed]
- Huang, X.; Groves, J.T. Oxygen Activation and Radical Transformations in Heme Proteins and Metalloporphyrins. Chem. Rev. 2018, 118, 2491–2553. [Google Scholar] [CrossRef] [PubMed]
- Donegan, R.K.; Moore, C.M.; Hanna, D.A.; Reddi, A.R. Handling heme: The mechanisms underlying the movement of heme within and between cells. Free Radic. Biol. Med. 2019, 133, 88–100. [Google Scholar] [CrossRef] [PubMed]
- Chambers, I.G.; Willoughby, M.M.; Hamza, I.; Reddi, A.R. One ring to bring them all and in the darkness bind them: The trafficking of heme without deliverers. Biochim. Biophys. Acta. Mol. Cell Res. 2021, 1868, 118881. [Google Scholar] [CrossRef] [PubMed]
- Gallio, A.E.; Fung, S.S.; Cammack-Najera, A.; Hudson, A.J.; Raven, E.L. Understanding the Logistics for the Distribution of Heme in Cells. JACS Au 2021, 1, 1541–1555. [Google Scholar] [CrossRef] [PubMed]
- Hamza, I. Intracellular trafficking of porphyrins. ACS Chem. Biol. 2006, 1, 627–629. [Google Scholar] [CrossRef] [PubMed]
- Hou, S.W.; Reynolds, M.F.; Horrigan, F.T.; Heinemann, S.H.; Hoshi, T. Reversible binding of heme to proteins in cellular signal transduction. Acc. Chem. Res. 2006, 39, 918–924. [Google Scholar] [CrossRef]
- Krishnamurthy, P.; Xie, T.; Schuetz, J.D. The role of transporters in cellular heme and porphyrin homeostasis. Pharmacol. Ther. 2007, 114, 345–358. [Google Scholar] [CrossRef]
- Franken, A.C.W.; Werner, E.R.; Haas, H.; Lokman, B.C.; van den Hondel, C.A.M.J.J.; Ram, A.F.J.; de Weert, S.; Punt, P.J. The role of coproporphyrinogen III oxidase and ferrochelatase genes in heme biosynthesis and regulation in Aspergillus niger. Appl. Microbiol. Biot. 2013, 97, 9773–9785. [Google Scholar] [CrossRef] [PubMed]
- Phillips, J.D.; Whitby, F.G.; Warby, C.A.; Labbe, P.; Yang, C.; Pflugrath, J.W.; Ferrara, J.D.; Robinson, H.; Kushner, J.P.; Hill, C.P. Crystal structure of the oxygen-dependant coproporphyrinogen oxidase (Hem13p) of Saccharomyces cerevisiae. J. Biol. Chem. 2004, 279, 38960–38968. [Google Scholar] [CrossRef] [PubMed]
- Besteiro, S.; Williams, R.A.M.; Morrison, L.S.; Coombs, G.H.; Mottram, J.C. Endosome sorting and autophagy are essential for differentiation and virulence of Leishmania major. J. Biol. Chem. 2006, 281, 11384–11396. [Google Scholar] [CrossRef] [PubMed]
- Noda, T.; Ohsumi, Y. Tor, a phosphatidylinositol kinase homologue, controls autophagy in yeast. J. Biol. Chem. 1998, 273, 3963–3966. [Google Scholar] [CrossRef] [PubMed]
- Pinan-Lucarré, R.; Paoletti, M.; Dementhon, K.; Coulary-Salin, B.; Clavé, C. Autophagy is induced during cell death by incompatibility and is essential for differentiation in the filamentous fungus. Mol. Microbiol. 2003, 47, 321–333. [Google Scholar] [CrossRef] [PubMed]
- Idnurm, A.; Heitman, J. Ferrochelatase is a conserved downstream target of the blue light-sensing White collar complex in fungi. Microbiology 2010, 156, 2393–2407. [Google Scholar] [CrossRef] [PubMed]
- Schrettl, M.; Kim, H.S.; Eisendle, M.; Kragl, C.; Nierman, W.C.; Heinekamp, T.; Werner, E.R.; Jacobsen, I.; Illmer, P.; Yi, H.; et al. SreA-mediated iron regulation in Aspergillus fumigatus. Mol. Microbiol. 2008, 70, 27–43. [Google Scholar] [CrossRef] [PubMed]
- Balla, J.; Balla, G.; Jeney, V.; Kakuk, G.; Jacob, H.S.; Vercellotti, G.M. Ferriporphyrins and endothelium: A 2-edged sword—Promotion of oxidation and induction of cytoprotectants. Blood 2000, 95, 3442–3450. [Google Scholar] [CrossRef] [PubMed]
- Kumar, S.; Bandyopadhyay, U. Free heme toxicity and its detoxification systems in human. Toxicol. Lett. 2005, 157, 175–188. [Google Scholar] [CrossRef]
- Letarte, P.B.; Lieberman, K.; Nagatani, K.; Haworth, R.A.; Odell, G.B.; Duff, T.A. Hemin—Levels in Experimental Subarachnoid Hematoma and Effects on Dissociated Vascular Smooth-Muscle Cells. J. Neurosurg. 1993, 79, 252–255. [Google Scholar] [CrossRef]
- Wagener, F.A.D.T.G.; Feldman, E.; deWitte, T.; Abraham, N.G. Heme induces the expression of adhesion molecules ICAM-1, VCAM-1, and E selectin in vascular endothelial cells. Proc. Soc. Exp. Biol. Med. 1997, 216, 456–463. [Google Scholar] [CrossRef]
- Gutteridge, J.M.; Smith, A. Antioxidant protection by haemopexin of haem-stimulated lipid peroxidation. Biochem. J. 1988, 256, 861–865. [Google Scholar] [CrossRef]
- Lavrovsky, Y.; Song, C.S.; Chatterjee, B.; Roy, A.K. Age-dependent increase of heme oxygenase–1 gene expression in the liver mediated by NFκB. Mech. Ageing Dev. 2000, 114, 49–60. [Google Scholar] [CrossRef] [PubMed]
- Sun, F.; Zhao, Z.; Willoughby, M.M.; Shen, S.; Zhou, Y.; Shao, Y.; Kang, J.; Chen, Y.; Chen, M.; Yuan, X.; et al. HRG-9 homologues regulate haem trafficking from haem-enriched compartments. Nature 2022, 610, 768–774. [Google Scholar] [CrossRef] [PubMed]
- Besur, S.; Schmeltzer, P.; Bonkovsky, H.L. Acute Porphyrias. J. Emerg. Med. 2015, 49, 305–312. [Google Scholar] [CrossRef] [PubMed]
- Bissell, D.M.; Anderson, K.E.; Bonkovsky, H.L. Porphyria. N. Engl. J. Med. 2017, 377, 862–872. [Google Scholar] [CrossRef]
- Shigeoka, S.; Ishikawa, T.; Tamoi, M.; Miyagawa, Y.; Takeda, T.; Yabuta, Y.; Yoshimura, K. Regulation and function of ascorbate peroxidase isoenzymes. J. Exp. Bot. 2002, 53, 1305–1319. [Google Scholar] [CrossRef] [PubMed]
- Liu, K.L.; Xu, S.; Xuan, W.; Ling, T.F.; Cao, Z.; Huang, B.K.; Sun, Y.G.; Fang, L.; Liu, Z.Y.; Zhao, N.; et al. Carbon monoxide counteracts the inhibition of seed germination and alleviates oxidative damage caused by salt stress in Oryza sativa. Plant Sci. 2007, 172, 544–555. [Google Scholar] [CrossRef]
- Tenhunen, R.; Marver, H.S.; Schmid, R. The enzymatic conversion of heme to bilirubin by microsomal heme oxygenase. Proc. Natl. Acad. Sci. USA 1968, 61, 748–755. [Google Scholar] [CrossRef] [PubMed]
- Vile, G.F.; Basu-Modak, S.; Waltner, C.; Tyrrell, R.M. Heme oxygenase 1 mediates an adaptive response to oxidative stress in human skin fibroblasts. Proc. Natl. Acad. Sci. USA 1994, 91, 2607–2610. [Google Scholar] [CrossRef]
- Choi, A.M.; Alam, J. Heme oxygenase-1: Function, regulation, and implication of a novel stress-inducible protein in oxidant-induced lung injury. Am. J. Respir. Cell Mol. Biol. 1996, 15, 9–19. [Google Scholar] [CrossRef] [PubMed]
- Chen, J.J.; London, I.M. Regulation of Protein-Synthesis by Heme-Regulated Eif-2-Alpha Kinase. Trends Biochem. Sci. 1995, 20, 105–108. [Google Scholar] [CrossRef]
- Ogawa, K.; Sun, J.; Taketani, S.; Nakajima, O.; Nishitani, C.; Sassa, S.; Hayashi, N.; Yamamoto, M.; Shibahara, S.; Fujita, H.; et al. Heme mediates derepression of Maf recognition element through direct binding to transcription repressor Bach1. EMBO J. 2001, 20, 2835–2843. [Google Scholar] [CrossRef] [PubMed]
- Zhang, L.; Hach, A. Molecular mechanism of heme signalling in yeast: The transcriptional activator Hap1 serves as the key mediator. Cell Mol. Life Sci. 1999, 56, 415–426. [Google Scholar] [CrossRef] [PubMed]
- Zhu, Y.H.; Hon, T.; Ye, W.Z.; Zhang, L. Heme deficiency interferes with the Ras-mitogen-activated protein kinase signaling pathway and expression of a subset of neuronal genes. Cell Growth Differ. 2002, 13, 431–439. [Google Scholar] [PubMed]
- Ochiai, N.; Fujimura, M.; Oshima, M.; Motoyama, T.; Ichiishi, A.; Yamada-Okabe, H.; Yamaguchi, I. Effects of iprodione and fludioxonil on glycerol synthesis and hyphal development in Candida albicans. Biosci. Biotechnol. Biochem. 2002, 66, 2209–2215. [Google Scholar] [CrossRef] [PubMed]
- Albertyn, J.; Hohmann, S.; Thevelein, J.M.; Prior, B.A. Gpd1, which encodes glycerol-3-phosphate dehydrogenase, is essential for growth under osmotic-stress in Saccharomyces cerevisiae, and its expression is regulated by the high-osmolarity glycerol response pathway. Mol. Cell Biol. 1994, 14, 4135–4144. [Google Scholar] [CrossRef] [PubMed]
- Norbeck, J.; Pahlman, A.K.; Akhtar, N.; Blomberg, A.; Adler, L. Purification and characterization of two isoenzymes of DL-glycerol-3-phosphatase from Saccharomyces cerevisiae: Identification of the corresponding GPP1 and GPP2 genes and evidence for osmotic regulation of Gpp2p expression by the osmosensing mitogen-activated protein kinase signal transduction pathway. J. Biol. Chem. 1996, 271, 13875–13881. [Google Scholar] [CrossRef]
- Petelenz-Kurdziel, E.; Kuehn, C.; Nordlander, B.; Klein, D.; Hong, K.K.; Jacobson, T.; Dahl, P.; Schaber, J.; Nielsen, J.; Hohmann, S.; et al. Quantitative Analysis of Glycerol Accumulation, Glycolysis and Growth under Hyper Osmotic Stress. PLoS Comput. Biol. 2013, 9, e1003084. [Google Scholar] [CrossRef]
- Furukawa, K.; Hohmann, S. A fungicide-responsive kinase as a tool for synthetic cell fate regulation. Nucleic Acids Res. 2015, 43, 7162–7170. [Google Scholar] [CrossRef]
- Zheng, Z.T.; Gao, T.; Zhang, Y.; Hou, Y.P.; Wang, J.X.; Zhou, M.G. FgFim, a key protein regulating resistance to the fungicide JS399-19, asexual and sexual development, stress responses and virulence in Fusarium graminearum. Mol. Plant Pathol. 2014, 15, 488–499. [Google Scholar] [CrossRef] [PubMed]
- Zheng, Z.T.; Gao, T.; Hou, Y.P.; Zhou, M.G. Involvement of the anucleate primary sterigmata protein FgApsB in vegetative differentiation, asexual development, nuclear migration, and virulence in Fusarium graminearum. FEMS Microbiol. Lett. 2013, 349, 88–98. [Google Scholar] [CrossRef] [PubMed]
- Livak, K.J.; Schmittgen, T.D. Analysis of relative gene expression data using real-time quantitative PCR and the 2(-ΔΔC(T)) Method. Methods 2001, 25, 402–408. [Google Scholar] [CrossRef] [PubMed]
- Li, B.; Liu, L.P.; Li, Y.; Dong, X.; Zhang, H.F.; Chen, H.G.; Zheng, X.B.; Zhang, Z.G. The FgVps39-FgVam7-FgSso1 Complex Mediates Vesicle Trafficking and Is Important for the Development and Virulence of Fusarium graminearum. Mol. Plant-Microbe Interact. 2017, 30, 410–422. [Google Scholar] [CrossRef] [PubMed]

| Strains | Tebuconazole | Fludioxonil | ||
|---|---|---|---|---|
| EC50 (μg/mL) z | MIC (μg/mL) | EC50 (μg/mL) z | MIC (μg/mL) | |
| PH-1 | 0.0422 ± 0.0030 c | 2 | 0.0313 ± 0.0036 d | 0.4 |
| PH-1 + hemin | 0.0616 ± 0.0044 a | 2 | 0.1136 ± 0.0047 a | 1.6 |
| ΔFgcpo + hemin | 0.0475 ± 0.0037 c | 0.5 | 0.0479 ± 0.0032 b | 0.4 |
| ΔFgfc + hemin | 0.0554 ± 0.0016 b | 0.5 | 0.0379 ± 0.0009 c | 0.4 |
Disclaimer/Publisher’s Note: The statements, opinions and data contained in all publications are solely those of the individual author(s) and contributor(s) and not of MDPI and/or the editor(s). MDPI and/or the editor(s) disclaim responsibility for any injury to people or property resulting from any ideas, methods, instructions or products referred to in the content. |
© 2024 by the authors. Licensee MDPI, Basel, Switzerland. This article is an open access article distributed under the terms and conditions of the Creative Commons Attribution (CC BY) license (https://creativecommons.org/licenses/by/4.0/).
Share and Cite
Wang, J.; Cao, Y.; Shi, D.; Zhang, Z.; Li, X.; Chen, C. Crucial Involvement of Heme Biosynthesis in Vegetative Growth, Development, Stress Response, and Fungicide Sensitivity of Fusarium graminearum. Int. J. Mol. Sci. 2024, 25, 5268. https://doi.org/10.3390/ijms25105268
Wang J, Cao Y, Shi D, Zhang Z, Li X, Chen C. Crucial Involvement of Heme Biosynthesis in Vegetative Growth, Development, Stress Response, and Fungicide Sensitivity of Fusarium graminearum. International Journal of Molecular Sciences. 2024; 25(10):5268. https://doi.org/10.3390/ijms25105268
Chicago/Turabian StyleWang, Jin, Yingying Cao, Dongya Shi, Zhihui Zhang, Xin Li, and Changjun Chen. 2024. "Crucial Involvement of Heme Biosynthesis in Vegetative Growth, Development, Stress Response, and Fungicide Sensitivity of Fusarium graminearum" International Journal of Molecular Sciences 25, no. 10: 5268. https://doi.org/10.3390/ijms25105268





